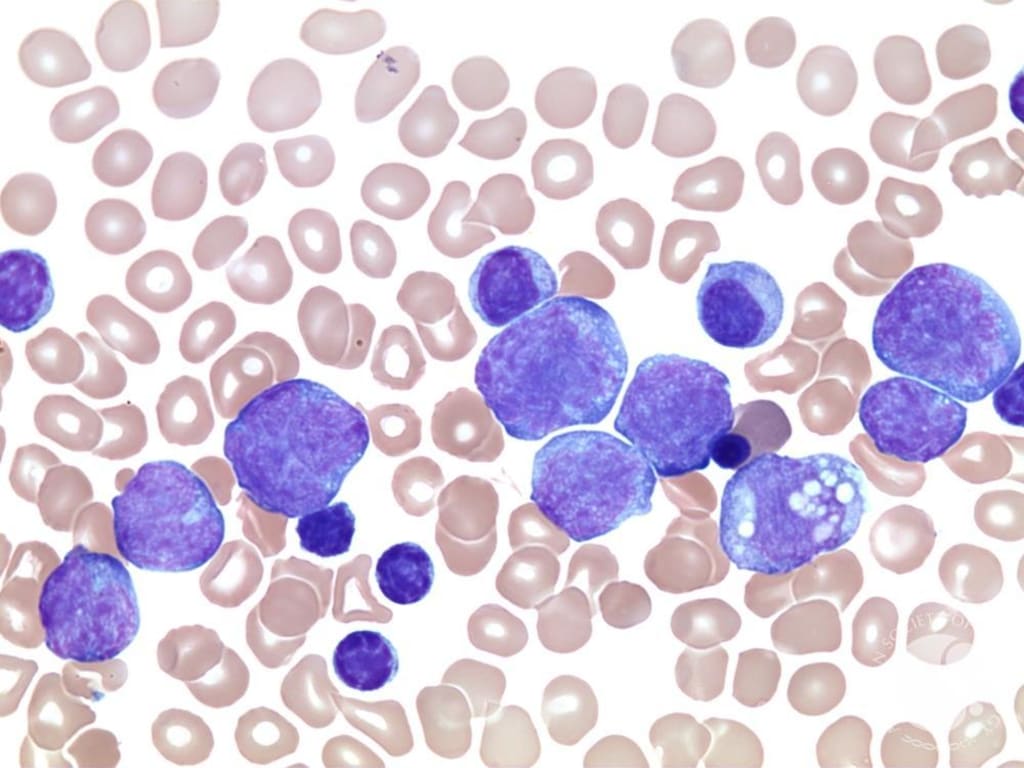

Richter's Syndrome Market Analysis, Epidemiology, Trends, Size, Share, and Future Forecast till (2023-2033)
The report offers competitor analysis, regional analysis, and recent advancements in the global market. The report also highlights key segments and market drivers, as well as challenges faced by industry players.
IMARC Group has recently released a report titled “Richter’s Syndrome Market: Epidemiology, Industry Trends, Share, Size, Growth, Opportunity, and Forecast 2023-2033” that presents a comprehensive assessment of the Richter’s syndrome market size, latest trends, and growth forecast. The report provides an overview of the market trends, growth prospects, investment opportunities, and industry prospects, as well as an analysis of the disease overview, market scenario, and growth trends.
Richter’s syndrome, also referred to as Richter’s transformation, is a rare and aggressive type of cancer that develops in individuals with chronic lymphocytic leukemia (CLL) or small lymphocytic lymphoma (SLL). Some of the symptoms of this condition are enlargement of the lymph nodes at a rapid pace, fever, weight loss, fatigue, night sweats, decreased appetite, shortness of breath, headache, and abdominal pain. The diagnosis of Richter’s syndrome includes a combination of physical exams, complete blood count tests, imaging studies, such as CT, PET, or MRI scans, and tissue biopsies. These assessments help the healthcare professional determine the extent of the disease and decide the course of treatment.
Request a Free Sample Report: https://www.imarcgroup.com/richters-syndrome-market/requestsample
Market Trend:
The rising incidence of aggressive lymphoma among individuals diagnosed with chronic lymphocytic leukemia and small lymphocytic lymphoma is primarily driving the Richter’s syndrome market. Furthermore, the escalating adoption of targeted therapy, which involves the utilization of drugs that target the B-cell receptor pathway to treat cancer, especially in patients who cannot go through chemotherapy, is acting as another significant growth-inducing factor.
Besides this, the introduction of various advanced diagnostic tools, including flow cytometry, molecular testing, imaging studies like PET-CT, etc., that aid in differentiating Richter’s syndrome from other forms of lymphoma and enhance the precision of the diagnosis is also augmenting the market growth.
Additionally, several leading players are increasingly investing in clinical trials to assess the safety and effectiveness of novel therapies for Richter’s syndrome, such as CAR T-cell therapy, which involves modifying a patient’s T-cells to attack and eliminate cancer cells. This, in turn, is anticipated to propel the Richter’s syndrome market in the coming years.
Report Period:
Base Year: 2022
Historical Period: 2017-2022
Market Forecast: 2023-2033
Countries Included:
United States
Germany
France
United Kingdom
Italy
Spain
Japan
Analysis Covered Across Each Country
Historical, current, and future epidemiology scenario
Historical, current, and future performance of the Richter’s syndrome market
Historical, current, and future performance of various therapeutic categories in the market
Sales of various drugs across the Richter’s syndrome market
Reimbursement scenario in the market
In-market and pipeline drugs
In-Market Drugs
Drug Overview
Mechanism of Action
Regulatory Status
Clinical Trial Results
Drug Uptake and Market Performance
Late-Stage Pipeline Drugs
Drug Overview
Mechanism of Action
Regulatory Status
Clinical Trial Results
Regulatory Status
Ask an Analyst for Report Customization with TOC & List of figures: https://www.imarcgroup.com/richters-syndrome-market
Key Questions Answered in this Report:
How has the Richter’s syndrome market performed so far and how will it perform in the coming years?
What are the markets shares of various therapeutic segments in 2022 and how are they expected to perform till 2033?
What was the country-wise size of the Richter’s syndrome market across the seven major markets in 2022 and what will it look like in 2033?
What is the growth rate of the Richter’s syndrome market across the seven major markets and what will be the expected growth over the next ten years?
What are the key unmet needs in the market?
About Us: –
IMARC Group is a leading market research company that offers management strategy and market research worldwide. We partner with clients in all sectors and regions to identify their highest-value opportunities, address their most critical challenges, and transform their businesses.
IMARC’s information products include major market, scientific, economic and technological developments for business leaders in pharmaceutical, industrial, and high technology organizations. Market forecasts and industry analysis for biotechnology, advanced materials, pharmaceuticals, food and beverage, travel and tourism, nanotechnology and novel processing methods are at the top of the company’s expertise.
Contact US
IMARC Group
134 N 4th St.
Brooklyn, NY 11249, USA
Email: [email protected]
Americas:- +1 631 791 1145 | Africa and Europe :- +44-702-409-7331 | Asia: +91-120-433-0800, +91-120-433-0800



Comments
There are no comments for this story
Be the first to respond and start the conversation.